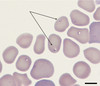

Ectoparasites - Cattle Flashcards
(59 cards)
Name the species of cattle-biting muscidae which is most common in the UK.
Stomoxys calcitrans
Outline the behaviour of S. calcitrans.
Rests and mates on sun-exposed walls, farm gates, posts and machinery. Prefers to feed on the lower animal (legs and flanks) Moves between animals and is therefore a good mechanical vector of pathogens.
Describe the lifecycle of S. calcitrans.

What negative effects can S. calcitrans have on cattle production?
- Blood loss
- Weight loss - 10-15%
- Decreased milk yield - 40%
- BVD
- Anthrax
*
Name and describe this species of biting fly.

- Lyperosia irritans
- Horn fly
- Bovine only
- Very small (like a mini s. calcitrans)
- Lays eggs on dung
- Semi-permanent - lives mainly on cow
Where would L. irritans be found feeding on cattle?
On the backs of cows
Name this species of fly.
Which part of the world is it mainly found?

Glossina or Tsetse fly. Restricted to sub-saharan Africa.
Outline the lifecycle of the Tsetse fly.

How many eggs will a female Tsetse fly produce at one time?
One
Which lifecycle stage of the Glossina spp. is found deposited on soil by the mother?
Fully-frown larva just prior to pupae
Name and describe three pathogens/ diseases which can be transmitted by the Tsetse fly.
- T. congolenses and other trypanosomes - protozoa
- Nagana - Anaemia, emmaciation, destruction of lymphnodes
- African sleeping sickness in humans
Differenciate between mechanical and cyclical transmission.
With cyclical transmission an intermediate insect vector is required before the pathogen can infect vertebrates whereas with mechanical transmission the disease agent does not require an insect vector.
Name three species of Trypanosome.
- Congolense
- Vivax
- Brucei
The species of trypanosome can be found within the blood stream of cattle, BUT is a non pathogenic protozoa.
What is it and what fly species transmits it?
Trypanosoma theileri
Name three non-biting species of fly which relate to cattle.
- Hydrotaea irritans
- Musca autumnalis
- Musca domestica
- Describe the morphological features of H. irritans.
- How many generations are produced a year?
- Which common summer condition does it cause?
- Green abdomen with orange wing base.
- One, emerging in summer
- August bag (summer mastitis)
August bag is mainly caused by which bacteria? (x3)
- Corynebacterium pyogenes
- Streptococcus dysgalactiae
- Peptococcus pyogenes
Infectious bovine keratoconjunctivitis can be transmitted by which non-biting species of fly?
Outline some features of the epidemiology of this fly.
Musca autumnalis
- Southern England
- Rare in north
- Found on eyes, muzzle and face
A tick shaped wing vein is characteristic of which species of non-biting cattle fly?
Musca autumnalis
Outline the methods of control used for fly control in cattle.
- Impractical to control larval stages in soil/dung
- Synthetic pyrethroids on cattle
- Barriers - teat tape, stockholm tar on teats
- Husbandry and hygiene
- Treat accommodation and surfaces
The warble fly is also known by what taxonomic name?
Hypoderma spp.
Name two species of warble fly which can infest cattle.
H. bovism, H. lineatum
How do the migratory routes of cattle warble fly differ between species?
- Bovis - Travels to spinal epidural fat
- Lineatum travel to the submucosa of oesophagous
Outline the lifecycle of the ox warble fly.